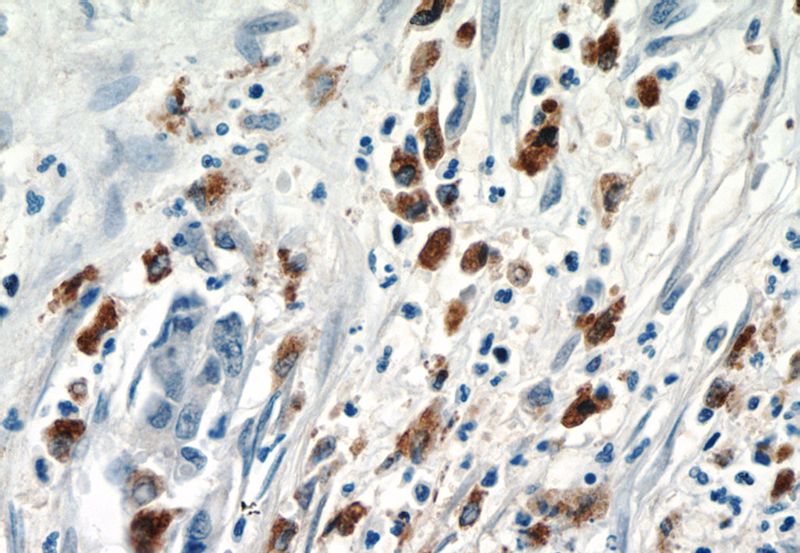
Immunohistochemistry of paraffin-embedded human pancreas cancer tissue slide using Catalog No:111937(ISG15 Antibody) at dilution of 1:50 (under 40x lens)

-
Product Name
ISG15 antibody
- Documents
-
Description
ISG15 Rabbit Polyclonal antibody. Positive IHC detected in human lung cancer tissue, human pancreas cancer tissue. Positive IP detected in HeLa cells. Positive WB detected in human brain tissue. Observed molecular weight by Western-blot: 15-17 kDa
-
Tested applications
ELISA, WB, IHC, IP
-
Species reactivity
Human; other species not tested.
-
Alternative names
G1P2 antibody; hUCRP antibody; IFI15 antibody; IP17 antibody; ISG15 antibody; ISG15 ubiquitin like modifier antibody; Ubiquitin like protein ISG15 antibody; UCRP antibody
-
Isotype
Rabbit IgG
-
Preparation
This antibody was obtained by immunization of ISG15 recombinant protein (Accession Number: NM_005101). Purification method: Antigen affinity purified.
-
Clonality
Polyclonal
-
Formulation
PBS with 0.02% sodium azide and 50% glycerol pH 7.3.
-
Storage instructions
Store at -20℃. DO NOT ALIQUOT
-
Applications
Recommended Dilution:
WB: 1:200-1:2000
IP: 1:200-1:2000
IHC: 1:20-1:200
-
Validations

human brain tissue were subjected to SDS PAGE followed by western blot with Catalog No:111937(ISG15 antibody) at dilution of 1:500

Immunohistochemical of paraffin-embedded human lung cancer using Catalog No:111937(ISG15 antibody) at dilution of 1:50 (under 40x lens)

IP Result of anti-ISG15 (IP:Catalog No:111937, 4ug; Detection:Catalog No:111937 1:500) with HeLa cells lysate 3200ug.
Immunohistochemistry of paraffin-embedded human pancreas cancer tissue slide using Catalog No:111937(ISG15 Antibody) at dilution of 1:50 (under 40x lens)
-
Background
ISG15 is a ubiquitin-like protein that becomes conjugated to many cellular proteins upon activation by interferon-alpha (IFNA) and -beta (IFNB). ISG15 forms covalent conjugates with its target proteins in a process called ISGylation, which in mammals is known to play a role in antiviral immunity. ISG15 proteins possess two ubiquitin-like (UBL) domains and a highly conserved C-terminal LRGG sequence, the latter being known as the ubiquitin conjugation motif. Intracellular ISG15 are conjugated, via the LRGG motif, to target proteins through a process called ISGylation, which resembles largely ubiquitination, the process of formation of ubiquitin conjugates. Unconjugated extracellular ISG15, which are released from several types of human and murine cells, are known to possess cytokine-like activity.
-
References
- Zhang W, Zhang L, Wu Z, Tien P. Differential interferon pathway gene expression patterns in Rhabdomyosarcoma cells during Enterovirus 71 or Coxsackievirus A16 infection. Biochemical and biophysical research communications. 447(3):550-5. 2014.
- Sainz B, Martín B, Tatari M, Heeschen C, Guerra S. ISG15 is a critical microenvironmental factor for pancreatic cancer stem cells. Cancer research. 74(24):7309-20. 2014.
Related Products / Services
Please note: All products are "FOR RESEARCH USE ONLY AND ARE NOT INTENDED FOR DIAGNOSTIC OR THERAPEUTIC USE"
